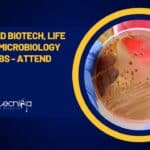
CLRI MSc, PhD Biotech, Life Sciences & Microbiology Project Jobs – Attend Walk-In CLRI Project Openings 2023

Home Search
biology - search results
If you're not happy with the results, please do another search
IQVIA BSc Life Sciences, Biotech, Biochem, Microbiology Job Opening, Apply Online
IQVIA BSc Life Sciences, Biotech, Biochem, Microbiology Job Opening, Apply Online
IQVIA BSc Life Sciences, Biotech, Biochem, Microbiology Job Opening, Apply Online. Interested and eligible...
Cipla Vacancy For BSc Microbiology Candidates – Online Application Process
Cipla Vacancy For BSc Microbiology Candidates - Online Application Process
Cipla Vacancy For BSc Microbiology Candidates - Online Application Process. BSc Microbiology Jobs. Interested and...
MACS-ARI Pune Project Associate Job For Biotech & Microbiology, Apply Online
MACS-ARI Pune Project Associate Job For Biotech & Microbiology, Apply Online
MACS-ARI Pune Project Associate Job For Biotech & Microbiology, Apply Online. MSc Microbiology and...
CLRI MSc, PhD Biotech, Life Sciences & Microbiology Project Jobs – Attend Walk-In
CLRI Project Openings 2023 For MSc, PhD Life Sciences - Attend Walk-In
CLRI Project Openings 2023 For MSc, PhD Life Sciences - Attend Walk-In. CLRI...
Bharat Serums and Vaccines Production Exec Job For BTech, MSc Biotech, Microbiology, Biochem Candidates
BSV Production Exec Job For BTech, MSc Biotech, Microbiology, Biochem Candidates
BSV Production Exec Job For BTech, MSc Biotech, Microbiology, Biochem Candidates. BSV job opening...
CSIR-IMMT MSc, MTech Biotech, Life Sciences, Microbiology P-JRF Job, Applications Invited
CSIR-IMMT MSc, MTech Biotech, Life Sciences, Microbiology P-JRF Job, Applications Invited
CSIR-IMMT MSc, MTech Biotech, Life Sciences, Microbiology P-JRF Job, Applications Invited. CSIR – Institute...
CSIR-IICT BSc & MSc Biotech, Genetics, Life Sciences, Biochem & Microbiology Job Opening, Attend...
CSIR-IICT Project Vacancies 2023 For BSc, MSc Life Sciences, Biotech, Biochem
CSIR-IICT Project Vacancies 2023 For BSc, MSc Life Sciences, Biotech, Biochem, Attend Walk-In. CSIR...
CDFD Bioinformatics, Mol Bio, Cell Bio, Biotech, Microbiology Project Jobs With Upto Rs. 78,000...
CDFD Bioinformatics Job, Mol Bio, Cell Bio, Biotech, Microbiology Project Jobs With Upto Rs. 78,000 pm
CDFD Bioinformatics Job, Mol Bio, Cell Bio, Biotech, Microbiology...
DRDO-DRDE JRF Jobs For Biological, Life Sciences, Mol Bio, Microbiology – Attend Walk-In
DRDO-DRDE JRF Jobs For Biological, Life Sciences, Mol Bio, Microbiology - Attend Walk-In
DRDO-DRDE JRF Jobs For Biological, Life Sciences, Mol Bio, Microbiology - Attend...
C-CAMP MSc Biology, BTech Biotech Facility Assistant – Mass Spectrometry Facility Job, Apply Online
C-CAMP MSc Biology, BTech Biotech Facility Assistant – Mass Spectrometry Facility Job, Apply Online
C-CAMP MSc Biology, BTech Biotech Facility Assistant – Mass Spectrometry Facility...
IMTECH Biotech, Microbiology & Biological Sciences Project Associate Job, Apply Online
IMTECH Biotech, Microbiology & Biological Sciences Project Associate Job, Apply Online
IMTECH Biotech, Microbiology & Biological Sciences Project Associate Job, Apply Online. MSc Microbiology/ Biotechnology/Biological...
NCCS Pune Multiple Research Project Opening For Mol Bio, Bioinformatics, Cell Biology Candidates
NCCS Research Vacancies In Multiple Projects Available, Apply Online
NCCS Research Vacancies In Multiple Projects Available, Apply Online. NCCS Pune Recruitment 2023. NCCS Pune Recruitment...
VIT Vellore Comp Biology & Bioinformatics Research Associate Job Opening, Apply Online
VIT Vellore Comp Biology & Bioinformatics Research Associate Job Opening, Apply Online
VIT Vellore Comp Biology & Bioinformatics Research Associate Job Opening, Apply Online. PhD...
NISER Biology, Biological/Life-Sciences Project Associate Job, Applications Invited
NISER Biology, Biological/Life-Sciences Project Associate Job, Applications Invited
NISER Biology, Biological/Life-Sciences Project Associate Job, Applications Invited National Institute of Science Education and Research Odisha Senior...
SASTRA MSc Biotech, Biochem, Microbiology, Bioinformatics Project Assistant Job
SASTRA MSc Bioinformatics, Biochem, Microbiology, Biotech Project Assistant Job
SASTRA MSc Bioinformatics, Biochem, Microbiology, Biotech Project Assistant Job. Interested and eligible applicants can check out...